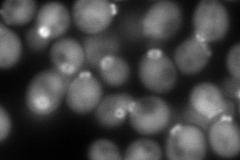
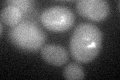

View description
Component of the septin ring of the mother-bud neck that is required for cytokinesis; septins recruit proteins to the neck and can act as a barrier to diffusion at the membrane, and they comprise the 10nm filaments seen with EM
Localization:
Intensity:
Fold change:
Significance:
-
C’ GFP library in SD

below threshold17.97 -
N' NOP1pr-GFP in SD

bud neck170.835 -
N' TEF2pr-mCherry in SD
bud neck297.402 -
N' NATIVEpr-GFP in SD

bud neck69.6627 -
N' TEF2pr-VC and Cyto-VN in SD

bud neck49.2682 -
C’ GFP library in SD+DTT
cytosolN/AN/ANo -
C’ GFP library in SD+H2O2

cytosol21.651.2No -
C’ GFP library in Starvation Media

cytosol20.761.15No -
C’ GFP library on the background of Pup2-DaMP

below threshold -
C’ GFP library on the background of CCT mutant

below threshold19.74261.09827No
